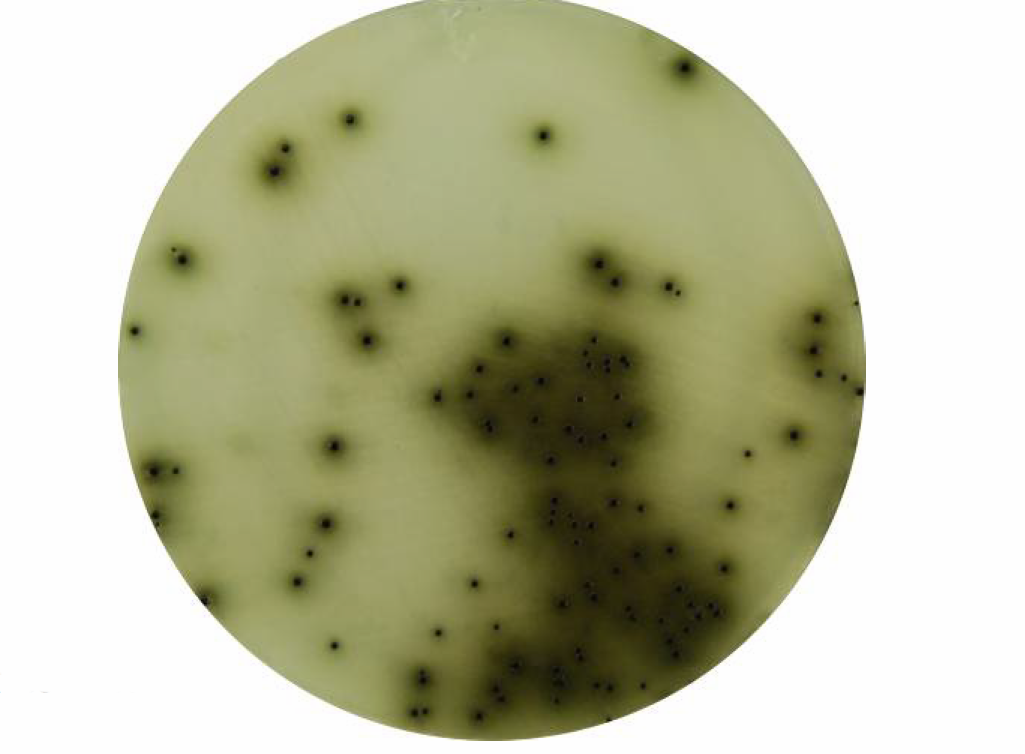
Bismuth Sulfite Agar - Bismuth Sulfite Agar

Bismuth sulfite agar (BS) is a selective as well as a differential medium for isolation and presumptive identification of Salmonellaspp, especially Salmonella Typhi. Salmonella spp are the causative agent of various diseases like gastroenteritis, sepsis, and enteric fever. Salmonella can be isolated from a wide range of clinical, food, sewage, and other environmental samples. Bismuth sulfite agar is a modification of the original Wilson and Blair Medium
Composition
Bismuth sulfite agar is selective due to the presence of inhibitors and is differential on the basis of hydrogen sulfide ( H2S) production. The presence of bismuth sulfite indicator and brilliant green inhibits the growth of Gram-positive bacteria and members of the coliform group while allowing Salmonella to grow luxuriantly.
| Ingredients | Gm / Litre |
|---|---|
| Peptone | 10 |
| Beef extract | 5 |
| Dextrose (Glucose) | 5 |
| Disodium phosphate | 4 |
| Ferrous sulphate | 0.3 |
| Bismuth sulphite indicator | 8 |
| Brilliant green | 0.025 |
| Agar | 20 |
| Final pH ( at 25°C) 7.7±0.2 |
Beef extract and peptones provide nitrogen, vitamins, and minerals needed for the growth of microorganisms.
Dextrose is the carbohydrate present that acts as a source of carbon.
Disodium phosphate is the buffering agent which maintains the osmotic equilibrium.
Ferrous sulfate is an indicator for hydrogen sulfide production, which occurs when the H2S produced by Salmonellareacts with the iron salt. This reaction causes a black or green metallic colony and brown or black precipitate whilst the reduction of bismuth ions to metallic bismuth produces a metallic luster around the colonies. Agar is the solidifying agent.
Note: Composition may vary according to themanufacturer. Some use enzymatic digest of casein and enzymatic digest of animal tissue instead of peptone. Glucose may be used as an alternative to dextrose. However, the inclusion purpose of each ingredient and quantity are the same.
Preparationof Media
- Suspend the required amount of dry powder (as per the manufacturer’s instruction) in 1000 ml of distilled water.
- Heat gently with frequent agitation until the medium just begins to boil and simmer for 30 seconds to dissolve the agar.
- DO NOT OVERHEAT – DO NOT AUTOCLAVE
- Cool to 50-55°C, mix well to disperse suspension, and pour plates (25 ml medium per plate).
NOTE: The sensitivity of the medium depends largely upon uniform dispersion of precipitated bismuth sulphite in the final medium; therefore the medium should be mixed well in a way that there should be no sedimentation of the indicator.
- Allow the medium to solidify, store at 2-8°C until use and dry the prepared plates before use.
Sample processing: Clinical specimens may be directly inoculated in the medium, or if the sample is considered to have a low organism load, it can be sub-cultured from an enrichment broth. For environmental samples, appropriate dilution or enrichment may be necessary before plating.
Result and interpretation
The colony morphologyof certain bacteria is illustrated as follows
| Organism | Appearance |
|---|---|
| Salmonella Typhi | Black`rabbit-eye’ colonies with a black zone and metallic sheen surrounding the colony after 18 hours. Uniformly black after 48 hours of incubation Note: When a heavy inoculum is used, S. Typhi appears light green and could be misinterpreted as negative growth. |
| Salmonella Paratyphi A and Other Salmonella spp | Variable colony appearance after 18 hours, they may be black, green, or clear and mucoid. Uniformly black colonies are seen after 48 hours, often with widespread staining of the medium and a pronounced metallic sheen |
| Other organisms like coliform bacteria, Serratia, Proteus | Usually inhibited but occasional strains give dull green or brown colonies with no metallic sheen or staining of the surrounding medium. |
Note:S. typhiandS. arizonaeare the only enteric organisms to exhibit typical brown zones in the medium; although,S.arizonaeis usually inhibited
Limitations
- Autoclaving/overheating the medium should be avoided as it destroys the selectivity of the medium.
- Due to its selectivity, Shigellaspecies (exceptS. flexneriandS. sonnei) and certain Salmonella like S. Sendai, S. Berta, S. Gallinarum, S. Abortusare also inhibited.
- Incubation of bismuth sulfite agar plates at higher temperatures (i.e., 43ºC.) results in small, atypical Salmonellacolonies and also reduces sensitivity showing significantly lower recovery.
- Although typical S. Typhicolonies usually develop within 24 hours, a further incubation up to 48 hours is required for growth of all typhoid strains.
- Prepared Bismuth Sulfite Agar plates should be used within 2 days. After 3 days of storage, there is a reduction in selectivity of the media, decreasing the number of Salmonellarecovered.
- Colonies on bismuth sulfite agar may be contaminated with other viable organisms; therefore, isolated colonies should be subcultured onto a less selective medium (i.e., MacConkey Agar)
References
- Gordeĭko, V. A., & Shustrova, N. M. (1989). The use of bismuth-sulfite-agar as a solid differential medium for isolating bacteria of the species Y. enterocolitica and Y. frederiksenii. Laboratornoe delo, (4), 64–65.
- Allen, S. B., Firstenberg-Eden, R., Shingler, D. A., Bartley, C. B., & Sullivan, N. M. (1993). Evaluation of Stabilized Bismuth Sulfite Agar for Detection of Salmonella in Foods. Journal of food protection, 56(8), 666–671. https://doi.org/10.4315/0362-028X-56.8.666